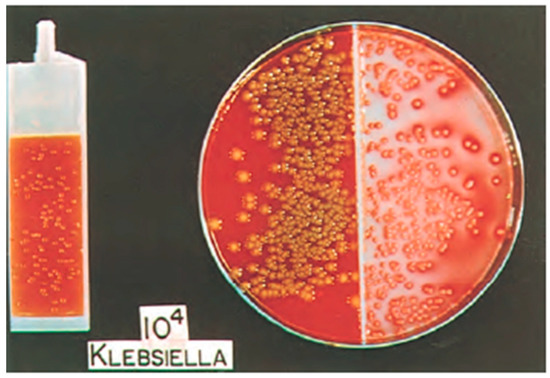

What Is The Meaning Of Sensitive In Urine Culture
Cefotetanand meropenem are the only sensitive beta-lactams Rule 2. This test can find and identify the germs that cause a urinary tract infection.
Predictability Of Urinalysis Parameters In The Diagnosis Of Urinary Tract Infection A Case Study Medical Laboratory Observer
Sensitivity analysis may be ordered if your infection doesnt respond to treatment.
What is the meaning of sensitive in urine culture. Explain why unnecessary urine cultures can lead to increases in catheter-associated urinary tract infection CAUTI reporting and resident harms. Test PRELIM RPT SOURCE. 03102017 URINE CULTURE ApprovedBy.
During an invasive collection technique urine is contaminated with a normal flora of urethra for this urine culture the quantitative estimation of colony. 26092008 The classification intermediate. 14062019 Urine culture and sensitivity testing is used to determine which antimicrobials will inhibit the growth of the bacteria or fungi causing a specific urinary tract infection UTI.
The sensitivity test helps caregivers pick the best medicine to treat your infection in-fek-shun. Urine culture and sensitivity is considered to be the gold standard for the diagnosis of asymptomatic bacteriuria of pregnancy. Urine Culture and Sensitivity Test A urine culture is a laboratory test that can identify specific types of germs that cause urinary tract infections.
Urine culture and sensitivity is used to diagnose and screen for diseases or medical conditions related to urinary tract infection for persons experiencing symptoms such as frequent and painful urination. Resistant means the bacteria can grow even if the drug is present. So urine culture and sensitivity must be done in all antenatal women.
Bacteria can rapidly grow and. If the test finds more than 100000 bacteria in a milliliter of urine it usually indicates an infection. This modest difference may be because our study population included some.
Intermediate means a higher dose of the antibiotic is needed to prevent growth. The urine culture is a test that detects and identifies bacteria and yeast in the urine which may be causing a urinary tract infection UTI. Io CATH COLONY COUNT 822016 640 AM RESULT.
Posted on September 23 2014. The results from urine culture and sensitivity test will help a healthcare practitioner determine which drugs are likely to be most effective in treating a persons urinary tract infection UTI. Susceptible means they cant grow if the drug is present.
14122020 a recurring urinary tract infection UTI an unresponsive case of pneumonia. 24102008 Urine culture is when a doctor orders a urine specimen to be evaluated in a lab to determine exactly what kind of bacteria are living in it and causing problems. Patients with significant urinary bacterial growth should be given appropriate parenteral antibiotic agents preoperatively intraoperatively and postoperatively to decrease the risk of.
Determine when or not to order urine cultures. If there are bacteria in your sample but the count is between 100 and 100000 this may be due to infection or contamination of the sample in which you will need another urine culture. Urine culture and sensitivity determinations are mandatory in preparation for transurethral procedures especially for patients with an indwelling catheter.
Keeping this in consideration what does sensitive and resistant mean in urine culture. This means the antibiotic is effective against the bacteria. Do not compare MICs between drugs Rule 3.
Reason to take urine culture and sensitivity test. Means that the organism may well be eliminated in body compartments that are easily accessible by the drug eg the urinary tract while the same antibiotic may not be adequately effective against the same organism if it is located at other sites eg the meninges. The kidneys a pair of bean-shaped organs located at the bottom of the ribcage in the right and left sides of the back filter wastes out of the blood and produce urine the yellow fluid that carries wastes out of the body.
24052011 According to the definition of the NIDRR all of the positive urine culture results were significant bacteriuria. Why do I need it. Bacteria are germs that cause infections.
Urine culture is performed to detect the organism that is the causative agent of UTI urinary tract infection. Because of the below symptoms you need to take this test. The drawback with urine culture and sensitivity is that it takes 48 hours for the report and the woman may not turn up with the report for treatment.
04032021 A urine culture is a method to grow and identify bacteria bak-teer-e-uh that may be in your urine. Means to grow and they. A urinary tract infection occurs when bacteria enter the urinary system through the urethra.
In another study of patients with SCI Dedeić-Ljubović and Hukić reported that 873 of samples had a positive urine culture. 26072017 A urine culture is a test that can detect bacteria in your urine. 822016 640 AM In Range Microbiology results Out of F CFIJmL Gram Negative Rods Id and Sensitivity to Fallow.
Utilize evidence-based communication strategies to more effectively communicate urine culture. Our study reported a positive urine culture rate of 748. 18032019 The test will be POSITIVE.
If you can use the drug with some exceptions Exceptions Cefotetanshould not be used for ESBL-producing organisms and is IV Meropenem is appropriate but is IV Ciprofloxacin is resistant so levofloxacin should not be used.
Urine Culture And Sensitivity Testing Why Guidance Uti Is Better
Urine Culture Lab Tests Online Au
Fast And Sensitive Automated Point Of Care Urine Dips American Academy Of Pediatrics
Importance Of Urine Culture Test In The Diagnosis Of Utis
Total Superoxide Dismutase T Sod Activity Assay Kit Hydroxylamine Method In 2021 Kit Activities Method
Pdf Culture And Sensitivity Pattern Of Urinary Tract Infection In Hospitalized Children In Patan Hospital
Urinalysis Results In Infants With Bacteremic Uti And Infants With Download Table
Urine Culture And Sensitivity Testing Why Guidance Uti Is Better
Neurosurgery Practice Questions And Answers 701 805 Neurogenic Shock Septicemia Trigeminal Neuralgia